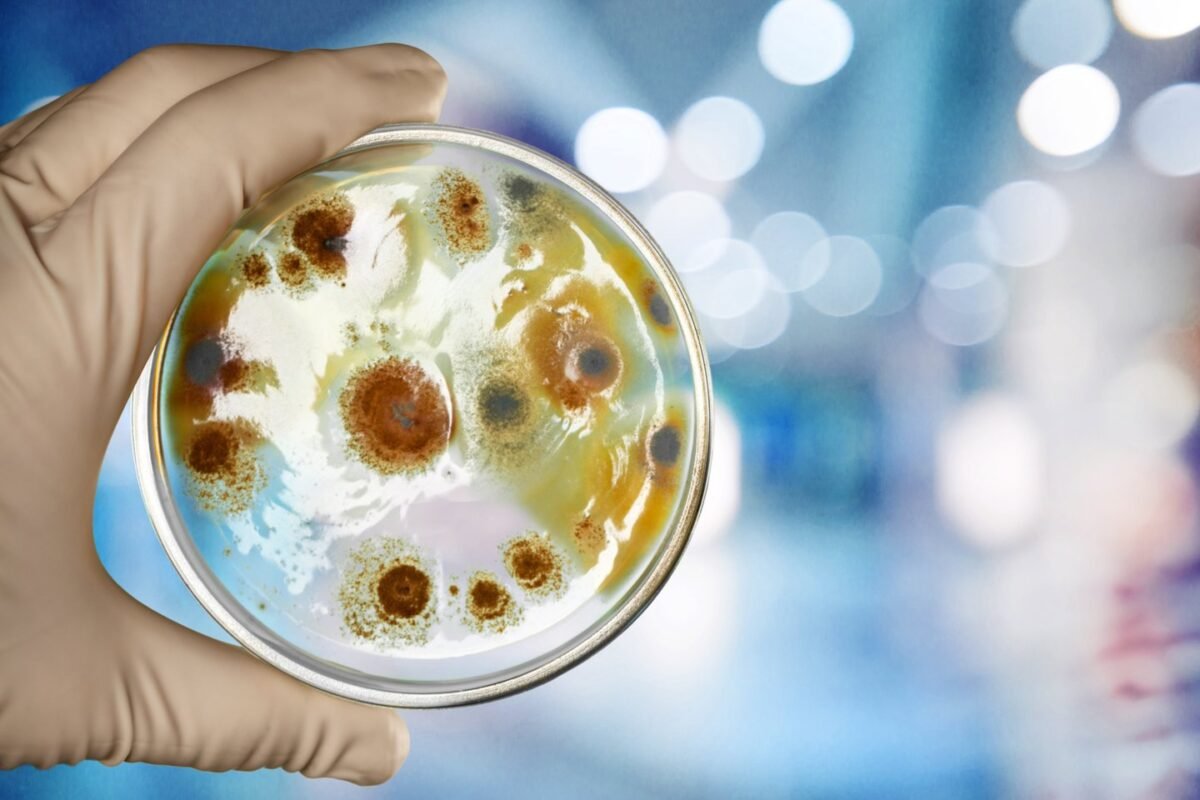

Antibiotikų atsparumas tampa viena didžiausių šiuolaikinės medicinos grėsmių visoje Europos Sąjungoje (ES). Pagal Europos ligų prevencijos ir kontrolės centro (ECDC) paskelbtus duomenis, dėl atsparumo antibiotikams kasmet ES šalyse miršta daugiau nei 35 tūkstančiai žmonių. Tai – rimtas signalas visuomenei ir sveikatos sistemoms, reikalaujantis skubaus dėmesio ir koordinuotų veiksmų.
ECDC direktorė Pamela Rendi-Wagner spaudos konferencijoje pažymėjo: „Šie skaičiai parodo, kad problema iš tiesų yra didelė“. Nepaisant kai kurios pažangos pastaraisiais metais, ES bendras antibiotikų suvartojimas iš tiesų didėjo. 2019–2023 m. laikotarpiu suvartojimas padidėjo 1 proc., nors numatytas ilgalaikis tikslas iki 2030 m. yra sumažinti antibiotikų vartojimą bent 20 proc. Šis neatitikimas rodo, kad pasiekti įsibrėžtus tikslus iki numatyto termino gali būti itin sudėtinga užduotis.
Skiriasi situacija tarp Europos valstybių
Analizuojant skirtingų ES valstybių situaciją, matyti dideli skirtumai. Pavyzdžiui, Suomija išsiskiria kaip šalis, kurioje antibiotikų suvartojimas 2019–2023 m. sumažėjo net 11,8 proc., ženkliai mažinant atsparumo riziką. Priešingai, Lietuvoje padėtis yra nerimą kelianti – antibiotikų suvartojimas per tą patį laikotarpį išaugo 14,9 proc., nors mūsų šaliai iškeltas tikslas yra sumažinti jų vartojimą 9 proc. iki 2030 m. Šie duomenys atskleidžia, jog Lietuvoje būtina dar aktyviau ir efektyviau įgyvendinti priemones kovai su atsparumu.
Didėjanti grėsmė pacientams ligoninėse
Kova su antibiotikų atsparumu – pagrindinės sritys
Europos ligų prevencijos ir kontrolės centras ragina spartinti veiksmus trijose esminėse srityse: infekcijų prevencijoje ir kontrolėje, atsargiu bei racionaliu antimikrobinių medžiagų naudojimu ir naujų antimikrobinių vaistų kūrimu bei prieinamumu. Šiuolaikinėje medicinoje antibiotikai yra itin svarbūs gydant daugelį infekcinių ligų, todėl jų nepagrįstas vartojimas, netaisyklingas paskyrimas ar per didelis naudojimas skatina bakterijų atsparumo vystymąsi.
Be pasienio vertinimų ir tinkamos priežiūros, antibiotikų atsparumas ne tik kelia grėsmę pacientų gyvybėms, bet ir apsunkina sveikatos priežiūros sistemas, kurios turi ieškoti brangesnių ir sudėtingesnių gydymo sprendimų. Tai taip pat reiškia ilgalaikes neigiamas socialines ir ekonomines pasekmes, kurios gali paveikti ne tik sergančiuosius, bet ir visą visuomenę.
Kaip kiekvienas gali prisidėti?
Kova su antibiotikų atsparumu yra kolektyvinė atsakomybė. Nuo medicinos specialistų tinkamo vaistų skyrimo iki kiekvieno paciento atsakingo požiūrio vartojant paskirtus antibiotikus. Neužbaigus pilno gydymo kurso arba vartojant antibiotikus nesergant bakterinėmis infekcijomis, stipriai prisidedama prie atsparumo didėjimo. Todėl svarbu šviesti visuomenę ir medicinos bendruomenę apie tinkamus antibiotikų vartojimo principus ir įgyvendinti veiksmingas prevencijos programas.
Galų gale, antibiotikų atsparumas yra didelė ir sudėtinga problema, kuri reikalauja bendradarbiavimo tiek nacionaliniu, tiek tarptautiniu lygiu. Toks bendras atsakas yra būtinas siekiant apsaugoti žmonių gyvybes ir išsaugoti veiksmingas gydymo priemones ateities kartoms.

Martyna Baranauskaitė – autorė, rengianti skaitytojams aktualų ir įdomų turinį įvairiomis temomis. Jos straipsniuose daug dėmesio skiriama aiškumui, informatyvumui ir sklandžiam pateikimui, kad skaitytojai greitai rastų naudingą ir suprantamai pateiktą informaciją.